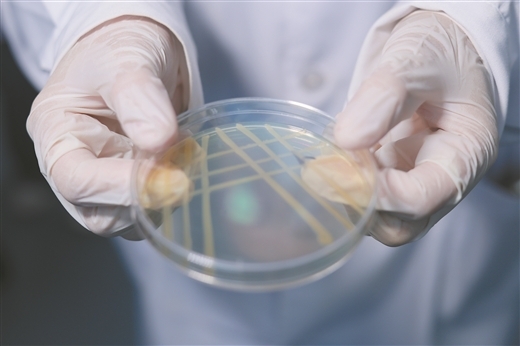

我要收藏
公共资源调用站点
文章分享

韦燕燕(左二)指导团队成员观察细菌生长情况。
位于培养皿中的芽孢杆菌LB2。

LB2菌株在硒镉伴生土壤中的作用机制图解。 (受访者供图)

广西大学·广西农业环境与农产品安金重点实验室
想象一下,你家里有个祖传的聚宝盆,里面既有能让你健康长寿的金色宝石(硒),也混杂着一些有毒的黑色铁钉(镉)。你想取出宝石,却又害怕被铁钉所伤。怎么办?
这正是广西部分地区农业发展面临的一个真实写照。
“以前看着大片富硒土壤却不敢放心种稻,现在有了LB2菌株,有望能让好土地产出安全粮!”在位于广西大学土化楼的实验室内,广西大学农学院韦燕燕副教授兴致勃勃介绍起最近的研究成果。近期,她带领团队与中山大学汤叶涛教授团队合作,成功找到一株芽孢杆菌LB2,可以一边活化土壤中的硒,将难以被植物吸收的硒释放出来给植物吸收,一边钝化土壤中的镉,把容易被植物吸收的镉钝化成难以被植物吸收的形态,实现水稻富硒降镉。
实验室里的培养皿中,这株被称为LB2的芽孢杆菌,或将成为破解富硒土壤“藏宝难取”困境的钥匙,为富硒水稻安全种植带来全新可能。
1 全国最大的富硒宝地,也有“先天不足”
你或许不知道,广西是全国最大的富硒宝地。
2021年自治区自然资源厅发布的广西土地质量地球化学评价工作结果显示,广西初步圈定富硒土壤分布面积7.57万平方公里,相当于1.14亿亩,居全国首位。更难得的是,这些富硒土壤不是零星分布,而是连片分布。
这不仅是自然的馈赠,也解释了为何广西拥有全国最多的“长寿之乡”。硒,这个被誉为“长寿元素”的微量元素,正静静地蕴藏在广阔田野中。“这让包括大米在内的不少富硒农产品物以‘硒’为贵,有了更高的产值。”广西农科院农业资源与环境研究所副所长、广西富硒农业研究中心主任刘永贤说。
然而,硬币有它的另一面。
包括广西在内的我国南方天然富硒土壤广泛存在“先天不足”——重金属镉含量常常超标,且土壤硒的有效性低。偏偏前者还是危害健康的重金属污染物。
富硒土壤为何会有这样的“先天不足”?
“土壤中广泛存在硒镉伴生,大多非人为造成,而是成土过程中的天然硬伤。”刘永贤解释。尤其在石灰岩多的区域,这些岩石会慢慢溶解,剩下的不溶物质又会继续风化形成土壤,这个过程会同时产生硒和镉。另外,广西的土壤里常见一种铁锰矿物,它像“吸附剂”一样,会同时把硒和镉都吸在土壤里。
更棘手的是,水稻作为亚洲主要粮食作物,其对镉的吸收能力极强,堪称“情有独钟”。这意味着,想要在富硒土壤上种出“硒多镉少”的大米,得经过土壤筛选、质量检验等“重重关卡”,这让不少稻农深受困扰。
“市面上的富硒大米为何价格会偏高?就是这些困扰造成的。”韦燕燕告诉记者,要种出合格富硒大米,有叶面喷施阻隔剂、施用土壤调理剂、筛选和培育低积累品种水稻等几种主流方案。但这些方案都有各自的短板,比如叶面喷施限制条件多且效果不稳定;土壤调理剂或钝化剂虽然可以钝化镉,却常常无法兼顾硒的活化;而筛选培育低积累品种的研发周期长,还可能伴随产量偏低、口感不佳等问题。
因此,对于已经存在的、硒镉共存的耕地,如何安全利用,把资源优势变成安全、高值的农产品,而不是弃之不用或冒着风险种植,成了广西发展富硒农业的一个关键考验。
2 不起眼的细菌,却身怀绝技
如何让水稻多富集硒、少吸收镉,种出安全又富硒的优质大米?这一难题,长期困扰着相关领域的科研人员。
“有没有一种办法,既能够稳定地实现‘活硒钝镉’,研发周期又不至于太长?”在这一领域深耕十余年,韦燕燕科研团队把目光转向了土壤中的细菌等微生物。
研究的起点是精准的“土壤侦探”工作。研究团队调研发现,部分区域土壤中硒和镉含量均较高,但种出的大米却能达到富硒标准且不超标。“我们推测是微生物在其中起作用。”韦燕燕说。
于是,研究团队从富硒区水稻根际这一“前沿阵地”分离微生物,且设定了清晰的筛选标准:兼具“活硒”与“钝镉”的双重能力。
“历时两年多开展试验,我们最终从广西富硒稻田的根际土壤中,成功分离出一种‘天赋异禀’的细菌——芽孢杆菌LB2。”韦燕燕介绍,该菌株不仅能让土壤中的硒活跃起来,转化为水稻可吸收的形态。同时还能将土壤中的镉钝化,也就是把活跃、可移动的镉,转化为不活跃、难移动的形态,阻止其被水稻吸收。
看着培养皿里不起眼的细菌,究竟是如何实现“活硒钝镉”的?
“你可以把它想象成一个派驻到水稻根系的‘全能管家’,拥有智能‘开锁’和‘关锁’两项核心技能。”韦燕燕进一步解释,这是一个从宏观现象深入到微观分子机制的研究过程。
“开锁”技能,即它能分泌出特殊的胞外代谢物质,这些代谢物来自色氨酸和嘌呤代谢过程,就像一把生物钥匙,能够“溶解”土壤中不能被水稻直接吸收的“固态硒矿”,将其转化为可吸收的“离子态硒”;“上锁”技能刚好相反,它能牢牢吸附固定住土壤中的游离镉离子,并形成稳定复合物,给有毒的镉“戴上镣铐”,从根源上阻止镉被水稻吸收。
盆栽试验表明了这位“管家”的高效:在硒、镉浓度为0.6mg/kg和1.2mg/kg的土壤中接种LB2菌株后,水稻生长态势显著改善。与对照组相比,水稻籽粒中硒含量提高20%~23%,镉含量则降低18.3%~36.6%。
LB2的厉害之处还不止于此。研究团队成员、广西大学农学院博士潘国飞告诉记者,研究还发现,LB2菌株就像是一位极具领导力的“项目经理”,一旦入驻水稻根际这个“微建筑工地”,就能通过代谢物招来其他微生物,发动“协同作战”,彻底改变那里的生态环境,达成促进水稻富硒降镉的目的。
例如,它能让擅长铁呼吸和硫酸盐呼吸的微生物功能得到强化,这些微生物会加速土壤中氧化物转化,使土壤硒的有效性最高提升36%,让镉的有效性最高降低17.69%。此外,它还可能通过嘌呤代谢产物招募更多功能微生物,共同打造“富硒降镉联盟”。
3 从实验室到田野,真正为水稻赋硒
该研究成果颇具意义。
其首次明确了芽孢杆菌LB2通过胞外代谢产物介导硒矿溶解与镉吸附的生理机制,填补了“功能菌株—代谢产物—硒镉形态转化”关联研究的空白。同时,研究创新性地揭示了根际微生物组重组是驱动水稻富硒降镉的核心路径,为解析土壤—微生物—植物系统中硒镉协同调控的生物地球化学过程提供了全新理论视角。LB2菌株可通过驱动微生物影响根际代谢产物,进而激活土壤硒并固定镉,无需化学药剂即可实现水稻富硒降镉。该研究还充分解析了LB2菌株的作用机制,这一系统性作用机制的揭示,为类似土壤重金属污染治理提供了重要参考。
其深深扎根于广西的现实需求。广西早已提出打造“中国富硒农业之都”的奋斗目标,富硒大米、富硒茶等产品也已颇具规模。然而,产业的可持续发展必须以安全为基石。LB2菌株及其揭示的“重塑微生物组”技术路径,恰好为解决硒镉伴生这一核心矛盾提供了全新的、绿色的、高效的生物解决方案。
这项突破,价值远不止于服务本地。根据2023年1月自然资源部中国地质调查局正式发布的《国家土地地球化学质量报告(2022)》,我国富硒的土地占比达16%,在全国各省(区、市)均有一定分布,适宜于发展富硒农业,提高农产品附加值,促进乡村振兴。“该成果为我国南方酸性土壤区富硒水稻绿色生产及农用地稻田土壤安全利用提供了一套新的‘内源’方案与思路。”刘永贤说。
不过,该成果目前只是在盆栽实验中得到验证,距离大规模应用,还需经过田间开展长期试验。未来,科研团队在验证其长期稳定性后,可通过企业合作等方式,将细菌制成可直接面向农户的标准化菌剂产品。
“我们希望,这项实验室里的科学发现能尽快走向田野,让遍布全国的‘健康宝藏’真正纯净、安全地惠及千家万户。”韦燕燕说。(广西云-广西日报记者 顾醒航 文/图)
文件下载:
关联文件: